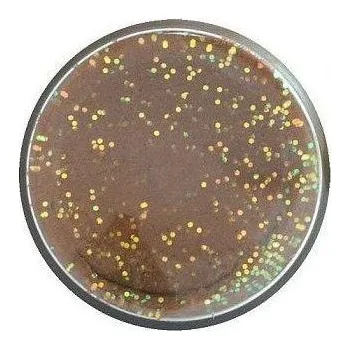
Nástraha Obalovací těsto Berkley PowerBait Natural Glitter Trout Dough 86gr Fish Pellet Glitter

PLOVOUCÍ BOILIES OCEAN TUNA 16mm STARBAITS
- Hmotnost 0,05 kg
HÁKOVÉ KULIČKY POP UP OCEAN TUNA 16 mm STARBAITS Hákové kuličky POP UP PERFORMANCE COCNCEPT OCEAN TUNA 16 mm, 50 g, značky…
v 2 obchodech

HÁKOVÉ KULIČKY POP UP OCEAN TUNA 16 mm STARBAITS Hákové kuličky POP UP PERFORMANCE COCNCEPT OCEAN TUNA 16 mm, 50 g, značky…
v 2 obchodech

Plovoucí hákové kuličky PERFORMANCE CONCEPT POP UP HOLD UP 14 mm 80 g od značky STARBAITS. ✅ Návnady HOLD UP jsou směsí…
v 3 obchodech

Atraktivní neutrálně vyvážená háčková nástraha. Wafters oceníte zejména při krátkodobém a rychlém lovu nebo pro lov…
v 4 obchodech

Starbaits Hard Boilies RS1 200g 20mm, Vytvrzené chytací boilie, které vydrží pod háčkem dlouhou dobu, aniž by ztrácelo…
v 4 obchodech

Pro Maple je boilie s výraznou plnou chutí a sladkou vůní javoru. Pro jeho výrobu byla použita kombinace precizně vybraných…
v 2 obchodech

Plovoucí boilies POP-UP se silným a intenzivním aroma kraba. Výrazná barva láká kapry i z velké vzdálenosti. Je plné…
v 6 obchodech

Plovoucí hákové kuličky PERFORMANCE CONCEPT POP UP HOLD UP 16 mm 50 g od značky STARBAITS. ✅ Návnady HOLD UP jsou směsí…
v 2 obchodech

Plovoucí boilies POP-UP se silným a intenzivním aroma raka.…
Arybarstvi.cz

STARBAITS BOILIES PROBIOTIC Squid Pepper Oliheň a Pepř, varianty průměrů 14 mm nebo 20 mm, balení 1 kg nebo 2.5 kg…
Arybarstvi.cz

STARBAITS Plovoucí boilies Omega Fish POP-UP, balení 80 g…
Arybarstvi.cz

HÁKOVÉ KULIČKY POP UP OCEAN TUNA 12 mm STARBAITS Hákové kuličky POP UP PERFORMANCE COCNCEPT OCEAN TUNA 12 mm, 50 g, značky…
Arybarstvi.cz

Rafinovaný olej nejvyšší kvality s tryskou pro vpravení do pevných sáčků nebo k postříkání návnady s příchutí Robin Red.…
v 6 obchodech

Dynamite Baits Monster Tiger Nut Boosted Hookbait Dip 100ml - nový vylepšený a zesílený koncentrovaný dip s příchutí tygřího…
Carpshop.cz

Při sestavování těchto pelet nám šlo hlavně o to, aby byly celoročně účinné. Sestavili jsme tak pelety, které jsou maximálně…
v 2 obchodech

Plandavka Hell-Cat 70g|Stříbrná, Tato plandavka je určena pro lov dravých ryb, jako jsou například sumci a štiky. Plandavka…
v 8 obchodech

Přinášíme novou řadu našich super atraktivních pop up.…
Freefishing.cz

Při sestavování těchto pelet nám šlo hlavně o to, aby byly celoročně účinné. Sestavili jsme tak pelety, které jsou maximálně…
v 3 obchodech

LiquiX je fluorescenční dip, který vaši nástrahu posune v atraktivitě o několik levelů výše. Díky své konzistenci se výborně…
v 9 obchodech

Přinášíme novou řadu našich super atraktivních pop-up ve stejných příchutích jako klasické boilie z této řady. Použijte jako…
v 3 obchodech

Droppen Vide má list ve tvaru vrbových listů, díky čemuž je perfektní rotačka pro rybolov v silném proudu a proti proudu.…
v 2 obchodech

zavalitý wobler se silnými vibracemi vhodný pro rychlé prochytání velké oblasti a lokalizaci dravců agresivní chod se silnou…
v 5 obchodech

Přinášíme novou řadu našich super atraktivních pop-up ve stejných příchutích jako klasické boilie z této řady. Použijte jako…
v 5 obchodech

Přinášíme novou řadu našich super atraktivních pop up. Rozhodli jsme se vytvořit samostatnou řadu plovoucího boilie přesně…
v 4 obchodech

Plovoucí boilies je velice atraktivní nástraha pro celoroční rybolov. Vyznačuje se vysokým vztlakem. Při výrobě byly použity…
v 12 obchodech

Speciální pevná a pružná jehla na pohodlnou a rychlou tvorbu návazců z pletených šňůr s olověným jádrem. Díky svojí…
v 2 obchodech

Při sestavování těchto pelet nám šlo hlavně o to, aby byly celoročně účinné. Sestavili jsme tak pelety, které jsou maximálně…
v 3 obchodech

HNV chytací boilies, samotná anglická zkratka mluví za vše.…
Freefishing.cz

Po delším vývoji, jsme přinesli zcela nové boostery, které jsme několik let vyvíjeli. Chtěl jsem připravit mix tekutých…
v 6 obchodech

Přinášíme novou řadu našich super atraktivních pop up. Rozhodli jsme se vytvořit samostatnou řadu plovoucího boilie přesně…
v 2 obchodech

Každá nástraha, aby byla úspěšná, se musí nějakým způsobem zatraktivnit. Existuje jistě několik způsobů, ale mezi ty…
v 2 obchodech

Přinášíme novou řadu našich super atraktivních pop-up ve stejných příchutích jako klasické boilie z této řady. Použijte jako…
v 3 obchodech

Vysoce účinné a cenově dostupné boilies. Nutra line je naší nejprodávanější řadou. Obsahuje absolutně vše co kapři milují a…
v 13 obchodech

Rotačka s dvěma křidýlky speciálně vyvinutá pro lov velkých štik. Druhé křidýlko přidává další lákavou vibraci. Pracuje…
v 2 obchodech

Série Club vychází z klasického základu 3000. Všechna krmení v této řadě jsou jemná, rychle pracují a dobře lákají ryby.…
v 2 obchodech

Ovocná řada PowerBait Troutdough je kolekcí ovocných vůní a barev, které odpovídají tomu nejlepšímu, co příroda nabízí.…
v 3 obchodech

The Kraken Pop-ups doplňují stejnojmennou řadu boilies a jsou na výběr ve třech barvách – přírodní, zářivě růžové a zářivě…
v 3 obchodech

Při sestavování těchto pelet nám šlo hlavně o to, aby byly celoročně účinné. Sestavili jsme tak pelety, které jsou maximálně…
v 3 obchodech

Přinášíme novou řadu našich super atraktivních pop up.…
Freefishing.cz

Zcela nové dipy, které jsou doslova „nabušené“ aminokyselinami a několika druhy HNV tekutých potrav. Po nadipování nástrahy…
v 4 obchodech
S nástrahami Berkley PowerBait jsou začínající rybáři dobří a dobří rybáři skvělí! Vědci společnosti Berkley strávili více…
v 5 obchodech

The Kraken Pop-ups doplňují stejnojmennou řadu boilies a jsou na výběr ve třech barvách – přírodní, zářivě růžové a zářivě…
v 4 obchodech

Přinášíme novou řadu našich super atraktivních pop up. Rozhodli jsme se vytvořit samostatnou řadu plovoucího boilie přesně…
v 3 obchodech

Řada woblerů vyrobená z ABS plastu určena především na pstruhy, okouny a tlouště. Každá nástraha je před expedicí testována.…
v 6 obchodech